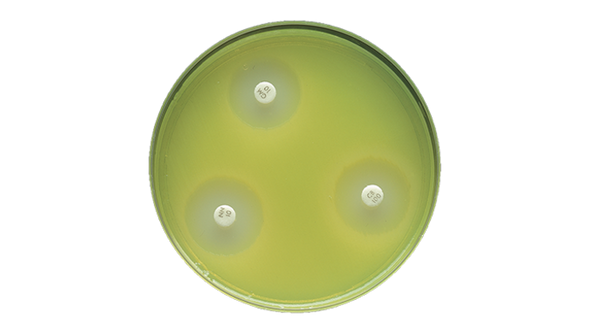
BD BBL Mueller Hinton II Agar 150mm Plate – 24 Pack, Controlled Thymine and Thymidine Levels

Description
BD BBL Mueller Hinton II Agar Plate is designed for laboratories that demand reliable antimicrobial susceptibility testing. When accuracy and consistency are essential, this prepared culture medium helps you maintain confidence in your results. Ideal for clinical microbiology labs and research facilities, its controlled composition supports standardized testing protocols.
- Controlled Thymine and Thymidine – Maintains low levels to prevent inhibition of sulfonamide and trimethoprim activity, supporting accurate antimicrobial testing.
- Calcium and Magnesium Regulation – Carefully screened raw materials ensure correct zone diameters with aminoglycoside test discs, giving you dependable results.
- CLSI-Recommended Medium – Addition of 5% sheep blood produces a medium suitable for Streptococcus pneumoniae susceptibility testing, offering peace of mind for specialized protocols.
- Pack of 100 Plates – Convenient quantity for routine lab workflows, reducing the need for frequent reordering.
Reliable Antimicrobial Susceptibility Testing for Clinical Labs
This prepared agar plate supports standardized antimicrobial susceptibility testing by maintaining strict control over thymine, thymidine, calcium, and magnesium levels. The formulation is designed to ensure that sulfonamide and trimethoprim activity are not inhibited, which is critical for accurate results. The medium also enables correct zone diameters when used with aminoglycoside-containing test discs. For labs testing Streptococcus pneumoniae, the addition of 5% sheep blood creates a CLSI-recommended environment. These features make this product a dependable choice for microbiology professionals who need consistency and reliability in daily testing routines.
Features and Benefits
Precision Formulation
- Low Thymine and Thymidine Content – Prevents interference with sulfonamide and trimethoprim, supporting precise antimicrobial susceptibility results.
- Controlled Mineral Levels – Calcium and magnesium are carefully regulated to ensure accurate zone diameters with aminoglycoside test discs.
Standardization and Compliance
- CLSI-Recommended for Streptococcus pneumoniae – Addition of 5% sheep blood creates a medium suitable for specific susceptibility testing protocols.
- Consistent Batch Quality – Raw materials are screened to maintain uniformity across all plates, giving labs confidence in every test.
Convenience for Laboratories
- Pre-Poured Plates – Ready to use, saving time and reducing preparation steps for busy lab staff.
- Bulk Packaging – Supplied as 100 plates per pack to support high-throughput environments.
Product Specifications
General Information
- Category: Prepared culture media
- Brand: BD BBL
- SKU: 221275
- GTIN (Each): 00382902212751
Packaging and Shelf Life
- Quantity Per Pack: 100 plates
- Shelf Life: 98 days
- GTIN (Shelfpack): 30382902212752
- GTIN (Bag): 10382902212758
- GTIN (US Standard Pallet): 60382902212753
Explore More: See all Prepared Culture Media | Shop more BD BBL Products
Dependable Results for Microbiology Professionals
Choose this agar plate for its precise formulation and batch-to-batch consistency. The controlled levels of thymine, thymidine, calcium, and magnesium set it apart from generic media, helping you achieve reliable results every time. Its CLSI-recommended composition supports specialized testing, while bulk packaging streamlines your workflow. Rely on this product for peace of mind and steady performance in your lab.
- Batch Consistency – Each plate is produced with strict quality controls, ensuring uniform results for every test.
- Specialized for Antimicrobial Testing – Designed to support a wide range of susceptibility protocols, including aminoglycoside and sulfonamide testing.
- Time-Saving Convenience – Pre-poured and ready to use, reducing setup time for laboratory staff.
- CLSI-Recommended Medium – Meets guidelines for Streptococcus pneumoniae testing, giving you confidence in compliance.
Frequently Asked Questions (FAQs)
What is the main use of this agar plate?
This product is used for antimicrobial susceptibility testing in clinical and research laboratories.
How does controlled thymine and thymidine benefit testing?
Low levels of these components prevent inhibition of sulfonamide and trimethoprim, supporting accurate results.
Why are calcium and magnesium levels important?
Regulated mineral content ensures correct zone diameters with aminoglycoside test discs, leading to dependable outcomes.
Is this medium recommended for Streptococcus pneumoniae testing?
Yes, the addition of 5% sheep blood creates a CLSI-recommended environment for this specific testing protocol.
How many plates are included in each pack?
Each pack contains 100 pre-poured agar plates for laboratory convenience.
What is the shelf life of the product?
The shelf life is 98 days, supporting efficient inventory management in the lab.
Does the product require any preparation before use?
No, the plates are pre-poured and ready to use, saving time for laboratory staff.